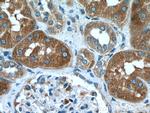
KLHDC5 Antibody in Immunohistochemistry (Paraffin) (IHC (P))

Search
Proteintech
KLHDC5 Polyclonal Antibody
{{$productOrderCtrl.translations['antibody.pdp.commerceCard.promotion.promotions']}}
{{$productOrderCtrl.translations['antibody.pdp.commerceCard.promotion.viewpromo']}}
{{$productOrderCtrl.translations['antibody.pdp.commerceCard.promotion.promocode']}}: {{promo.promoCode}} {{promo.promoTitle}} {{promo.promoDescription}}. {{$productOrderCtrl.translations['antibody.pdp.commerceCard.promotion.learnmore']}}
产品信息
24847-1-AP
种属反应
宿主/亚型
分类
类型
抗原
偶联物
形式
浓度
规格
纯化类型
保存液
内含物
保存条件
运输条件
产品详细信息
Immunogen sequence: FHEVLCKPQ FHLLGSPPQA PGDVSLKQRL REARMTGTPV LVALGDFLGG PLAPHPYQGE PPSMLRYEEM TERWFPLANN LPPDLVNVRG YGSAILDNYL FIVGGYRITS QEISAAHSYN PSTNEWLQVA SMNQKRSNFK LVAVNSKLYA IGGQAVSNVE CYNPEQDAWN FVAPLPNPLA EFSACECKGK IYVIGGYTTR DRNMNILQYC PSSDMWTLFE TCDVHIRKQQ MVSVEETIYI VGGCLHELGP NRRSSQSEDM LTVQSYNTVT RQWLYLKENT SKSGLNLTCA LHNDGIYIMS RDVTLSTSLE HRVFLKYNIF SDSWEAFRRF PAFGHNLLVS SLYLPNKAET (157-505 aa encoded by BC137116)
靶标信息
Substrate-specific adapter of a BCR (BTB-CUL3-RBX1) E3 ubiquitin-protein ligase complex required for mitotic progression and cytokinesis. The BCR(KLHL42) E3 ubiquitin ligase complex mediates the ubiquitination and subsequent degradation of KATNA1. Involved in microtubule dynamics throughout mitosis. [UniProt]
仅用于科研。不用于诊断过程。未经明确授权不得转售。
篇参考文献 (0)
生物信息学
蛋白别名: Ctb9; Cullin-3-binding protein 9; kelch domain containing 5; Kelch domain-containing protein 5; Kelch-like protein 42; unnamed protein product
基因别名: A330079N23Rik; AI450355; C230080I20Rik; Ctb9; KIAA1340; KLHDC5; KLHL42; mKIAA1340
UniProt ID: (Human) Q9P2K6, (Mouse) Q8BFQ9
Entrez Gene ID: (Human) 57542, (Mouse) 232539